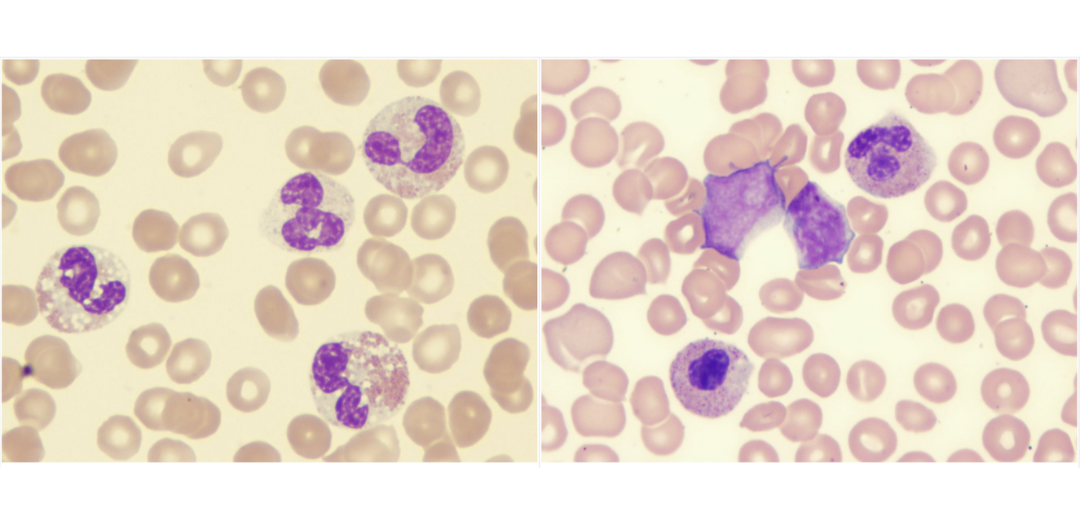

Studies to date have shown that mesenchymal stem cells (MSCs) are an attractive source of tissue engineering and regenerative medicine due to their self-renewal capacity and multi-lineage differentiation potential [1]. Although bone marrow and adipose tissue are the major sources of scientific research and clinical therapy, they have certain limitations, including low proliferation and differentiation…
Similarities and Differences between Dental Pulp and Umbilical Cord Stem Cells